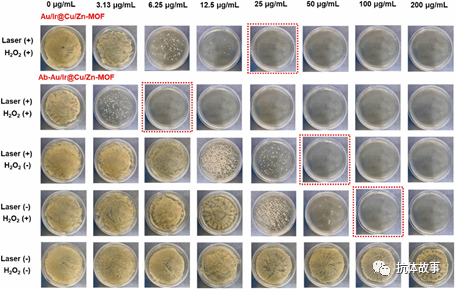
圖片

抗體偶聯(lián)Au/Ir@Cu/Zn-MOF探針用于細(xì)菌側(cè)流免疫分析和協(xié)同抗菌治療
發(fā)布時間:2023-09-09 14:34:56來源:抗體故事
【摘要】
金黃色葡萄球菌(S. aureus)是對公眾健康最普遍的威脅之一。具有高靈敏度的快速檢測和有針對性的殺傷對于遏制其傳播至關(guān)重要。本文中,構(gòu)建了一種含金屬的納米復(fù)合材料,由雙金屬納米顆粒和金屬有機框架(Au/Ir@Cu/Zn-MOF)構(gòu)成。在與抗-S. aureus抗體(Ab)結(jié)合時,這種納米復(fù)合材料(Ab-Au/Ir@Cu/Zn-MOF)具有雙重功能,即作為側(cè)流免疫測定中的報告探針和高效抗菌試劑。得益于Cu/Zn-MOF對Au/Ir納米顆粒(nanoparticles,NPs)的富集,基于Au/Ir@Cu/Zn-MOF的側(cè)流免疫測定傳感器顯示出103CFU/mL的視覺檢測極限,其靈敏度是基于Au/Ir的傳感器的100倍。此外,Ab-Au/Ir@Cu/Zn-MOF探針具有協(xié)同的光熱和化學(xué)動力學(xué)殺菌作用,特異性靶向S. aureus。在H2O2(0.4 mM)和808 nm近紅外輻射(1 W/cm2,5 min)的共同處理下,在納米復(fù)合材料濃度低至6.25 μg/mL時,實現(xiàn)了對5×105-106CFU/mLS. aureus的完全滅菌。優(yōu)異的抗菌效果歸因于Ab-Au/Ir@Cu/Zn-MOF探針的三重特性:(1)增強了促進(jìn)活性氧生成的多酶模擬活性,(2)高光熱活性(效率為53.70%),以及(3)通過抗體涂層靶向細(xì)菌的能力。通過改變抗體,這種納米復(fù)合材料可以針對廣泛的細(xì)菌種類進(jìn)行定制,用于檢測和精確的抗菌治療。
【引言】
傳統(tǒng)的基于金納米顆粒(Au NPs)的側(cè)流免疫分析(LIFA)作為傳感材料的靈敏度不令人滿意。例如,預(yù)包裝食品(乳制品、肉制品、冷凍飲料等)中S. aureus的最高安全限量103CFU/mL(GB 29921-2021),對于使用Au NPs的S. aureus的視覺LFIA,檢測限(LOD)約為106CFU/mL,不足以進(jìn)行食品安全監(jiān)管。近年來,雙金屬NPs由于其模擬酶的活性和突出的光學(xué)性質(zhì),成為LFIA中備受追捧的信號探針。例如,我們小組創(chuàng)建了基于Au@Ru雙金屬納米復(fù)合材料的LIFA用于快速靈敏地檢測鼠傷寒沙門氏菌,LOD為9.8×104CFU/ml。R. Zhang等人(2021)建立了雙拉曼分子標(biāo)記的Au@Ag核殼納米顆粒用于快速、超靈敏和定量地檢測糞便中的輪狀病毒。然而,據(jù)我們所知,很少有基于雙金屬納米粒子的LFIA用于檢測金黃色葡萄球菌的相關(guān)研究報告。
為了控制細(xì)菌污染和細(xì)菌感染,應(yīng)在識別出存在的細(xì)菌后立即進(jìn)行有效的殺滅和治療。為了解決抗生素耐藥性問題,已經(jīng)開發(fā)了多種新興的抗菌療法,如基于局部溫度升高的光熱療法(PTT)、基于模擬酶活性產(chǎn)生活性氧(ROS)的化學(xué)動力學(xué)療法(CDT),通過光催化產(chǎn)生ROS的光動力療法(PDT)等。這些策略可以單獨用作單模抗菌策略,另一方面,開發(fā)利用多模式策略的協(xié)同抗菌策略可以產(chǎn)生更有效的抗菌效果。在各種協(xié)同策略中,PTT和CDT的組合已被廣泛研究。盡管基于納米材料的PTT-CDT策略具有很高的有效性,但在正常情況下,PTT和CDT效應(yīng)產(chǎn)生的熱量和ROS也會對周圍的正常組織和細(xì)胞造成損傷。因此,對特定細(xì)菌物種的選擇性靶向是十分重要的。已知抗體可特異性識別細(xì)菌細(xì)胞并與細(xì)菌細(xì)胞緊密結(jié)合??贵w結(jié)合的抗菌納米材料不僅減少了對正常組織和細(xì)胞的損傷,抗體與細(xì)胞表面基序的結(jié)合還縮短了抗菌材料與細(xì)菌之間的距離,從而增強了抗菌效果,因而利用抗體修飾納米復(fù)合材料開發(fā)精確的PTT-CDT協(xié)同抗菌平臺具有廣闊的前景。
已知大多數(shù)納米顆粒易于聚集,這可能會削弱或失去其所需的膠體性質(zhì)。另一方面,良好分散的納米顆粒在用作傳感探針時具有有限的信號強度,因此靈敏度有限。金屬有機框架(MOFs)是一類具有多孔結(jié)構(gòu)的材料。MOFs由于其高比表面積和較大的負(fù)載能力,已被廣泛用作各種物質(zhì)(如酶、抗菌藥物等)的支撐基質(zhì)。通過物理吸附或共沉淀將納米顆粒裝載到MOFs中有望避免不必要的聚集,同時有助于濃縮納米顆粒。當(dāng)抗體配體與nanoparticle@MOF結(jié)合形成Ab-nanoparticle@MOF探針,將導(dǎo)致LFIA試條上的信號強度增強,從而提高細(xì)菌檢測的靈敏度和靶向細(xì)菌的能力。
在本工作中,通過還原合成了Au/Ir雙金屬納米顆粒(Au/Ir NPs),然后通過共沉淀將其負(fù)載到Cu/Zn-MOF中以獲得Au/Ir@Cu/Zn-MOF復(fù)合材料。接下來,將復(fù)合物與抗-S. aureus抗體(Ab)偶聯(lián)。利用靜電相互作用制備了Ab-Au/Ir@Cu/Zn-MOF探針,并建立LFIA傳感器,用于檢測S. aureus和精確的光熱-化學(xué)動力學(xué)(PTT-CDT)協(xié)同抗菌處理(Fig. 1)。以MOF的對應(yīng)物Au/Ir NPs為參考,來證明Cu/Zn-MOF富集Au/Ir NPs的重要性,從而將用于S. aureus檢測的Au/Ir@Cu/Zn-MOF-LIFA的靈敏度提高了100倍,其靈敏度是傳統(tǒng)Au NPs-LIFA的1000倍。此外,測試了Ab-Au/Ir@Cu/Zn-MOF探針對S. aureus的精確PTT-CDT協(xié)同殺菌作用,顯示出優(yōu)異的性能。進(jìn)行了詳細(xì)的實驗來證實該探針具有優(yōu)異的光熱轉(zhuǎn)換能力和ROS產(chǎn)生能力,以及良好的基于抗體的細(xì)菌靶向能力??傮w而言,本研究開發(fā)的Ab-Au/Ir@Cu/Zn-MOF探針是一種雙功能納米復(fù)合材料,適用于S. aureus的快速檢測和高效殺菌。

Fig. 1(a)Ab-Au/Ir@Cu/Zn-MOF探針的合成示意圖,(b)基于Ab-Au/Ir@Cu/Zn-MOF探針的細(xì)菌側(cè)流免疫測定,以及(c)Ab-Au/Ir@Cu/ZnMOF探針的抗菌應(yīng)用和抗菌機制(Ab靶向/光熱療法(PTT)/化學(xué)動力學(xué)療法(CDT))。
【研究內(nèi)容】
1.基于Ab-Au/Ir@Cu/Zn-MOF探針制備的LFIA傳感器
為實現(xiàn)特異性側(cè)流免疫測定和對細(xì)菌的精確抗菌,通過靜電相互作用將抗-S. aureusIgG(Ab)與Au/Ir@Cu/Zn-MOF復(fù)合材料結(jié)合。通過Zeta電位證實了Ab-Au/Ir@Cu/Zn-MOF探針的成功制備,詳細(xì)討論在“支持信息”中進(jìn)行了描述。此外,每個Au/Ir@Cu/Zn-MOF納米復(fù)合材料的共軛Abs的數(shù)量通過使用Bradford測定法,測量結(jié)合前后抗-S. aureusIgG溶液的濃度變化來測定。利用這種Ab-Au/Ir@Cu/Zn-MOF探針,設(shè)計了競爭性橫向流動測試(Fig. 1b),其中測試線(T線)涂有S. aureus,對照線(C線)用山羊抗兔IgG包被。當(dāng)樣品不含S. aureus時,在偶聯(lián)物墊中噴灑的Ab-Au/Ir@Cu/Zn-MOF探針可以與T線(通過抗體和S. aureus相互作用)和C線(通過兔IgG和抗兔IgG相互作用)結(jié)合,從而導(dǎo)致T線和C線顯色。相反,當(dāng)樣品含有S. aureus時,Ab-Au/Ir@Cu/Zn-MOF探針優(yōu)先與樣品中的S. aureus結(jié)合,使金黃色葡萄菌在T線上捕獲的數(shù)量減少,表現(xiàn)為T線減輕。此類樣品S. aureus/Ab-Au/Ir@Cu/Zn-MOF探針復(fù)合物不會影響C線強度,因為C線捕獲了所有已結(jié)合或未結(jié)合S. aureus的Ab-Au/Ir@Cu/Zn-MOF探針。因此,可以根據(jù)T線的顏色變化直觀快速地檢測樣品中S. aureus的濃度。
2.使用構(gòu)建的LFIA條帶檢測S. aureus
通過制備參數(shù)的優(yōu)化,制備了用于S. aureus檢測的LFIA條帶。如Fig. 2a所示,隨著樣品中S. aureus濃度的增加,T線的顏色逐漸變淺。當(dāng)S. aureus的濃度增加到103CFU/mL時,它明顯比空白組顏色更淺,表明其vLOD為103 CFU/mL。其qLOD經(jīng)計算為3.39×102CFU/mL,T線的顏色強度與S. aureus濃度的對數(shù)在101-105CFU/mL范圍內(nèi)線性相關(guān),R2為0.983(Fig. 2b)。為了證實Cu/Zn-MOF在增強探針強度和LFIA靈敏度方面的作用,構(gòu)建了基于Au/Ir的LIFA條帶進(jìn)行比較。從Fig. 2c和Fig. 2d可以發(fā)現(xiàn),基于Au/Ir的LIFA條帶的vLOD和qLOD分別為105CFU/mL和3.66×104CFU/mL,比Au/Ir@Cu/Zn-MOF-LIFA傳感器的靈敏度低近100倍。較高的靈敏度可歸因于Cu/Zn-MOF在Au/Ir NPs富集中的作用,導(dǎo)致條帶上較高的顏色強度。其次,Au/Ir@Cu/Zn-MOF的Zeta電位比Au/Ir更低,以及明顯更大的尺寸(Fig. S1a)都導(dǎo)致Au/Ir@Cu/Zn-MOF探針中有更多的抗體涂層,這有助于進(jìn)一步增強其靈敏度。這可以從Fig. S4c中得到初步驗證,Ab貢獻(xiàn)的Ab-Au/Ir@Cu/Zn-MOF探針的Zeta電位(14.75 mV)顯著高于Ab-Au/Ir探針(3.66 mV)。此外,通過Ab濃度變化測量(Bradford測定法)每個Au/Ir NPs綴合的Abs數(shù)量為147±27,顯著低于每個Au/Ir@Cu/Zn-MOF納米復(fù)合材料綴合的數(shù)量(566±31),也進(jìn)一步證實了上述結(jié)果。
此外,為了評估儲存穩(wěn)定性,我們測試了Au/Ir@Cu/Zn-MOF-LFIA傳感器在4 ℃的vLOD,獲得的vLOD同樣為103CFU/mL(Fig. S7a),表明本工作中制備的LFIA傳感器具有可接受的儲存穩(wěn)定性。除了靈敏度和儲存穩(wěn)定性檢測外,還評估了Au/Ir@Cu/Zn-MOF-LIFA傳感器用于S. aureus檢測的特異性。從Fig. S7b可以看出,只有S. aureus(107CFU/mL)和混合組能夠使T線的顏色從條帶上消失,而單獨的其他6種干擾細(xì)菌則不能,甚至它們的濃度都是S. aureus的100倍,可滿足對目標(biāo)S. aureus進(jìn)行特異性鑒定的基本要求。

Fig. 2 LFIA傳感器用于檢測S. aureus。(a)基于Ab-Au/Ir@Cu/Zn-MOF-LFIA傳感器檢測磷酸鹽緩沖液(PBS)中的S. aureus的結(jié)果,(b)使用Ab-Au/Ir@Cu/Zn-MOF- LFIA傳感器檢測S. aureus的定量結(jié)果和校準(zhǔn)曲線,(c)基于Ab-Au/Ir-LFIA傳感器在PBS中檢測S. aureus的結(jié)果,(d)使用基于Ab-Au/Ir-LFIA的S. aureus檢測的定量結(jié)果。(b)和(d)中的誤差條表示3次測定的標(biāo)準(zhǔn)偏差。
3.在真實樣品中檢測S. aureus
為了探索所建立的Au/Ir@Cu/Zn MOF-LIFA傳感器在實際樣品分析中的可行性,將S. aureus添加到不同領(lǐng)域的真實樣品中,包括食品樣品(維他奶和橙汁)和水環(huán)境樣品(珠江水)。如Fig. 3所示,隨著S. aureus濃度的增加,T線上的信號強度逐漸減弱,這表明LIFA傳感器在實際樣品檢測中仍然對S. aureus反應(yīng)靈敏。
它們的vLOD均為103CFU/mL,與PBS系統(tǒng)中的相同。該vLOD可達(dá)到食品中S. aureus的最高安全限值(103CFU/mL)(GB 29921-2021)。此外,該LIFA傳感器在實際樣品中檢測S. aureus的準(zhǔn)確性也通過回收試驗進(jìn)行了評估。結(jié)果顯示(Table S3),加標(biāo)S. aureus的平均回收率在89.87%-105.84%之間,相對標(biāo)準(zhǔn)偏差(RSD)值不超過5.68%。這樣的準(zhǔn)確度水平,使得該LFIA傳感器在實際樣品中顯示出良好的現(xiàn)場檢測金黃色葡萄菌的潛力。

Fig. 3 Ab-Au/Ir@Cu/Zn-MOF-LFIA傳感器檢測實際樣品中的S. aureus。(a)維他奶、(b)橙汁和(c)珠江水。
4. Ab-Au/Ir@Cu/Zn-MOF探針的體外協(xié)同抗菌作用及儲存穩(wěn)定性
鑒于本工作中獲得的Ab-Au/Ir@Cu/Zn-MOF探針不僅具有優(yōu)異的光熱性能并且憑借其多酶模擬活性具有ROS產(chǎn)生能力,而且還通過偶聯(lián)抗-S. aureusIgG,具有精確的光熱-化學(xué)動力學(xué)(PTT-CDT)協(xié)同抗菌治療的潛力。于是,研究了Ab-Au/Ir@Cu/Zn-MOF探針對S. aureus的體外功效。
從Fig.4和Fig. S14a可以發(fā)現(xiàn),在沒有808 nm近紅外光照射和H2O2的情況下,純Ab-Au/Ir@Cu/Zn-MOF探針即使在200 μg/mL的高濃度下,也只能殺死約39.84%的細(xì)菌。然而,當(dāng)向系統(tǒng)中加入0.4 mM H2O2時(該濃度接近細(xì)菌感染傷口中測得的量,即0.1-0.25 mM,遠(yuǎn)低于傷口消毒常用的量,如100-1000 mM),或用808 nm近紅外光照射5 min,Ab-Au/Ir@Cu/Zn-MOF探針在濃度分別為100 μg/mL和50 μg/mL時可完全滅活細(xì)菌。更令人驚訝的是,Ab-Au/Ir@Cu/Zn-MOF探針在低至6.25 μg/mL的濃度下,經(jīng)H2O2和808 nm近紅外光共同處理,可達(dá)到100%的殺菌效果。殺菌效果分別是單獨用H2O2或808 nm近紅外光處理的殺菌效果的16倍和8倍。這要歸功于Au/Ir@Cu/Zn-MOF復(fù)合材料優(yōu)異的光熱性能和多酶模擬活性。此外,還可以發(fā)現(xiàn)無Ab偶聯(lián)的Au/Ir@Cu/Zn-MOF復(fù)合材料在H2O2和808 nm近紅外光共處理下的完全殺菌濃度為25 μg/mL,比Ab-Au/Ir@Cu/Zn-MOF探針高4倍。這是由于Ab對Ab-Au/Ir@Cu/Zn-MOF探針的細(xì)菌靶向作用,可以使得Au/Ir@Cu/Zn-MOF復(fù)合物更接近細(xì)菌,使產(chǎn)生的ROS和局部高溫能更有效地殺滅細(xì)菌。一般來說,Ab-Au/Ir@Cu/Zn-MOF探針通過其Ab靶向能力、多酶模擬活性和光熱性能,可以實現(xiàn)精確的協(xié)同高效抗菌效果。此外,從Fig. S14b中可以發(fā)現(xiàn),6.25 μg/mL Ab-Au/Ir@Cu/Zn-MOF探針在4 ℃長達(dá)14天,這表明本工作中制備的Ab-Au/Ir@Cu/Zn-MOF探針具有可接受的儲存穩(wěn)定性。
Fig. 4S. aureus(ATCC 6538)與不同濃度的Ab-Au/Ir@Cu/Zn-MOF探針或Au/Ir@Cu/Zn-MOF復(fù)合材料在存在或不存在0.4 mM H2O2和/或808 nm激光照射(1 W/cm2)的情況下于37 ℃中共同孵育24 h后的菌落照片。
【結(jié)論】
本研究成功制備了由雙金屬NPs(Au/Ir)和Cu/Zn-MOF組成的雙功能金屬納米復(fù)合材料,用于S. aureus的快速靈敏側(cè)流免疫分析(LFIA)和體外精確光熱-化學(xué)動力學(xué)協(xié)同抗菌治療。由于Cu/Zn-MOF富集Au/Ir NPs,開發(fā)的Au/Ir@Cu/Zn-MOF-LFIA傳感器能夠?qū)崿F(xiàn)對S. aureus的高靈敏度檢測,視覺檢測限為103CFU/mL,比基于Au/Ir的LIFA傳感器低100倍。此外,該傳感器在實際樣品中檢測S. aureus時也表現(xiàn)出足夠的特異性、可行性和準(zhǔn)確性。得益于優(yōu)異的光熱性能和多酶模擬活性(過氧化物酶-過氧化氫酶-氧化酶模擬活性),以及抗體的細(xì)菌靶向作用,Ab-Au/Ir@Cu/Zn-MOF探針可以在體外實現(xiàn)精確的光熱-化學(xué)動力學(xué)協(xié)同抗菌效果。在H2O2和808 nm近紅外激光的共同作用下,納米復(fù)合材料在6.25 μg/mL的低濃度下完全滅活細(xì)菌。
然而,值得注意的是,當(dāng)應(yīng)用于治療細(xì)菌感染時,這種Ab綴合的Au/Ir@Cu/Zn-MOF探針(通過物理吸收制備)可能受到細(xì)菌環(huán)境中復(fù)雜生物介質(zhì)的影響,導(dǎo)致Ab從Au/Ir@Cu/Zn-MOF上脫落,從而失去其細(xì)菌靶向功能。為此,設(shè)想將探針結(jié)合到多孔水凝膠中(制作水凝膠敷料或軟膏等),不僅可以預(yù)防Ab-Au/Ir@Cu/Zn-MOF在復(fù)雜的生物介質(zhì)中不會散開,還能去除用過的Ab-Au/Ir@Cu/Zn-MOF和死細(xì)菌細(xì)胞,降低納米材料對生物體的潛在毒性和炎癥的發(fā)生率。
【原文出處】
Zhong, Y., Zheng, X. T., Li, Q. L., Loh, X. J., Su, X., & Zhao, S. (2023). Antibody conjugated Au/Ir@Cu/Zn-MOF probe for bacterial lateral flow immunoassay and precise synergistic antibacterial treatment.Biosensors & bioelectronics,224, 115033.


